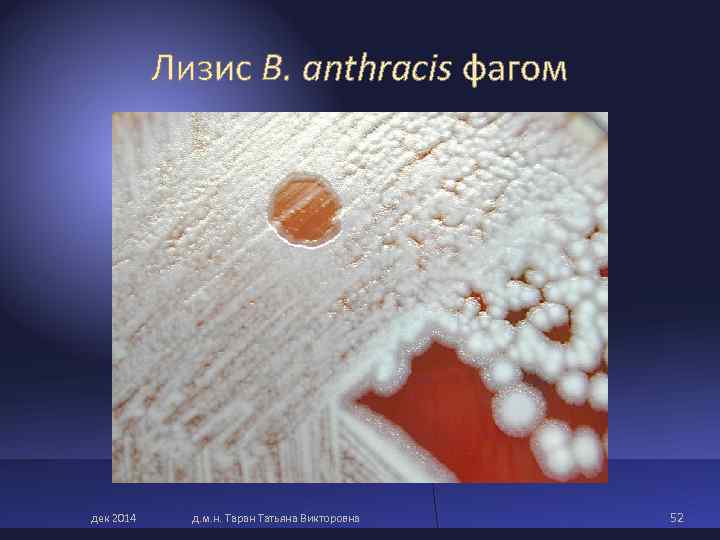
Лизис B. anthracis фагом дек 2014 д. м. н. Таран Татьяна Викторовна Лизис B. anthracis фагом дек 2014 д. м. н. Таран Татьяна Викторовна

ООИ: Чума Туляремия Anthrax spores in the

ООИ 14дек 2014 (2).pptx
- Количество слайдов: 71
ООИ: Чума Туляремия Anthrax spores in the lung Бруцеллез Сибирская язва
Правила по санитарной охране территории распространяются на холеру, чуму, желтую лихорадку (карантинные болезни); контагиозные вирусные геморрагические лихорадки (Ласса, Марбург, Эбола); малярию и другие опасные для человека инфекционные болезни ООИ – опасные для жизни и склонные к быстрому эпидемическому (пандемическому) распространению Высокая степень опасности – микроорганизм часто вызывает тяжелое заболевание у людей, но возможность передачи возбудителя болезни от человека к человеку отсутствует или является незначительной; Высокая степень опасности эпидемического распространения инфекции – микроорганизм часто вызывает тяжелое заболевание у людей; он может легко передаваться другим людям путем прямого контакта или опосредованно дек 2014 д. м. н. Таран Татьяна Викторовна 2
Для окончательного диагноза, как правило, требуется выделение чистой культуры, идентификация до вида и характеристика дополнительных свойств выделенных штаммов возбудителя (токсигенность и др. ) – идентификация; - этиологический диагноз; В диагностике ООИ широко используют ускоренные и экспресс-методы, т. к. они позволяют в короткие сроки определить факт наличия возбудителя – индикация, что, в свою очередь, определяет своевременность начала противоэпидемических мероприятий и лечения больного дек 2014 д. м. н. Таран Татьяна Викторовна 3
Зоонозные (природноочаговые) инфекции Зоонозные инфекции — инфекционные заболевания, передающиеся человеку от животных. К ним относятся чума, туляремия, сибирская язва, бруцеллез, ящур, туберкулез, листериоз и многие другие. Причиной заболевания человека может быть контакт с животным, укусы блох (клещей), данного животного, употребление мяса и молока от больных животных, яиц больной птицы. дек 2014 д. м. н. Таран Татьяна Викторовна 4
Пандемии чумы (возбудитель - Yersinia pestis) I пандемия - «Юстинианова» чума возникла в 6 веке н. э. в Восточно-Римской империи, длилась 50 лет; II пандемия - «Черная смерть» наблюдалась в 14 в, погибло 25 млн человек; III пандемия - последняя пандемия чумы в 1894 г. , охватила 87 портов и городов Европы, Северной Америки и Австралии. дек 2014 д. м. н. Таран Татьяна Викторовна 5
v Возбудитель чумы открыт в 1894 г. Китазато и Иерсеном во время эпидемии чумы в Гонконге; v В 1893 г. Владимир Хавкин в Бомбее приготовил вакцину (убитую) против чумы и испытал её на себе; v В 1918 г в г. Саратове создан противочумный институт «Микроб» Создатель первой в мире вакцины от чумы Владимир Хавкин проводит вакцинацию местного населения. Калькутта, 1893 год дек 2014 д. м. н. Таран Татьяна Викторовна 6
Типы природных очагов чумы Два типа природных очагов чумы: v Континентальные очаги ( «дикая» , степная чума) приурочены к пустынным, степным, горным ландшафтам и охватывают большие территории v Океанические очаги – очаги «крысиной» чумы, связаны с крысой дек 2014 д. м. н. Таран Татьяна Викторовна 7
Пункты проявления чумы за последние 50 лет дек 2014 д. м. н. Таран Татьяна Викторовна 8
Yersinia pestis – возбудитель чумы Y. pestis относится к семейству Enterobacteriaceae, роду Yersinia. Вызывает чуму - острую зоонозную природно-очаговую инфекцию. Чума характеризуется тяжелым течением с сильной интоксикацией, лихорадкой, поражением кожи, лимфатических узлов, легких и других органов, высокой летальностью. Относится к особо опасным, карантинным (конвенционным) болезням. Источником чумы являются около 250 видов диких животных, основное значение имеют грызуны (суслики, сурки и др. ). Антропонозные очаги формируются вокруг больного легочной формой чумы. От животных к человеку возбудитель чаще всего передается через укусы блох. дек 2014 д. м. н. Таран Татьяна Викторовна 9
ØY. pestis - мелкие (0, 5 × 1, 75 мкм) грам(-) палочки овоидной формы с биполярной окраской. ØНеподвижные, спор не образуют. ØМогут иметь нежную капсулу (в организме человека). Yersinia pestis. Чистая культура. Окр. по Граму дек 2014 д. м. н. Таран Татьяна Викторовна 10
Чумной микроб в гное из бубона (окраска метиленовым синим) Электронная микроскопия МФА дек 2014 д. м. н. Таран Татьяна Викторовна 11
Особенности возбудителя чумы Ø Факультативные анаэробы. Психрофилы (оптимум роста иерсиний 28 0 С), хотя микробы могут расти в пределах от 2 -40 0 С. Ø Ферментативная активность высокая. Ø Возбудитель имеет группу белково-полисахаридных и ЛПС антигенов: термостабильный соматический O-антиген и термолабильный капсульный, в том числе V- и W-антигены, с которыми связывают вирулентность бактерий. Ø Другими факторами высокой вирулентности Y. pestis являются плазмокоагулаза, фибринолизин, эндотоксин, капсула. Ø Y. pestis проявляет высокую цитотоксическую, антифагоцитарную и адгезивную активность, кодируемую плазмидными генами дек 2014 д. м. н. Таран Татьяна Викторовна 12
Формы чумы локальная форма (кожная, бубонная и кожно- бубонная) – в такой форме чумной микроб во внешнюю среду практически не попадает (хотя инфекция может передаваться укусившим больного блохам и даже клопам). генерализованная форма (первично и вторично- септическая) с повышенным рассеиванием микроба во внешнюю среду, первично-лёгочная, вторично-лёгочная кишечная – с обильным выбросом микробов. дек 2014 д. м. н. Таран Татьяна Викторовна 13
Бубонная чума дек 2014 д. м. н. Таран Татьяна Викторовна 14
Септическая и лёгочная чума Бубонная чума может перейти в септическую форму, которая проявляется болью в животе, интоксикацией и кровотечениями, или – во вторичную лёгочную чуму. Первично лёгочная чума – результат вдыхания аэрозоля, активно передаётся от человека к человеку. дек 2014 д. м. н. Таран Татьяна Викторовна 15
Профилактика и лечение чумы Ø Специфическая профилактика – живая противочумная вакцина ЕВ Ø Лечение – антибиотики аминоглюкозиды: стрептомицин, гентамицин и др. Тетрациклиновый ряд - доксициклин дек 2014 д. м. н. Таран Татьяна Викторовна 16
Диагностика чумы v РИФ, ПЦР, ИФА (ускоренные методы), имеют большое значение, т. к. позволяют своевременно начать лечение больного, а также противоэпидемические мероприятия; v Микробиологический диагноз: бактериоскопия, выделение чистой культуры и ее идентификация, биологическая проба на животных. v Диагностику проводят в специализированных лабораториях особо опасных инфекций. дек 2014 д. м. н. Таран Татьяна Викторовна 17
Туляремия ( возбудитель Francisella tularensis) Francisella tularensis – возбудитель туляремии - зоонозной, природноочаговой инфекции, характеризующейся лихорадкой, интоксикацией, поражением лимфатических узлов (бубонная, язвенно-бубонная, ангинозно-бубонная и глазобубонная формы болезни), дыхательных путей, нарушением целостности покровов. Резервуар и источник инфекции - грызуны (свыше 80 видов): водяные крысы, обыкновенные полевки, домовые мыши, ондатры, зайцы и др. От человека возбудитель не передается. Пути передачи: среди животных возбудитель передается через иксодовых клещей, комаров, реже - блох, слепней и гамазовых клещей; человек заражается контактным, алиментарным и воздушно-пылевым путями, реже трансмиссивно. дек 2014 д. м. н. Таран Татьяна Викторовна 18
Основные носители возбудителя туляремии в природе: Домовая мышь Ø домовые мыши Ø обыкновенные полевки Ø лесные мыши Ø серый хомячок Обыкновенная Ø заяц и др. полевка Заяц с присосавшимися клещами Лесная мышь 19 Серый хомячок дек 2014 д. м. н. Таран Татьяна Викторовна
дек 2014 д. м. н. Таран Татьяна Викторовна 20
v Франциселлы - мелкие палочковидные (0, 2 -0, 7 х 0, 7 -1, 7 мкм) грамотрицательные бактерии, полиморфны, неподвижны, не имеют пилей, окружены тонкой капсулой. v Требовательны к факторам роста, инкубация минимум 3 дня. v Содержат оболочечный (поверхностный) Vi-Аг и соматический – О –Аг. v Вирулентные и иммуногенные свойства связаны с Vi-Аг v Имеют антигенную близость с бруцеллами. v Различают 3 подвида франциселл: неарктический, голарктический, среднеазиатский. дек 2014 д. м. н. Таран Татьяна Викторовна 21
Факторы вирулентности F. tularensis Факторы вирулентности Биологический эффект Ингибирование лизосомальной функции Внутриклеточный фагоцитов, благодаря чему бактерии могут паразитизм длительно находиться в макрофагах ретикулоэндотелиальной системы Капсула (оболочечный Защита от фагоцитоза антигенный комплекс – Vi-Аг) Менее активен, чем эндотоксин других Эндотоксин (ЛПС) грамотрицательных палочек (например, E. coli) дек 2014 д. м. н. Таран Татьяна Викторовна 22
Патогенез туляремии Возбудитель попадает в организм человека через кожу, слизистые оболочки глаз, дыхательных путей, ЖКТ. Способы заражения человека обусловливают развитие тех или иных клинических форм туляремии. В патогенезе туляремии выделяют несколько фаз: Ø внедрение и первичная адаптация возбудителя; Ø лимфогенное распространение; Ø первичные регионарно-очаговые и общие реакции организма; Ø гематогенные метастазы и генерализация процесса; Ø вторичные очаги; Ø реактивно-аллергические изменения; Ø обратный метаморфоз и выздоровление. дек 2014 д. м. н. Таран Татьяна Викторовна 23
Клинические формы туляремии Бубонная Язвенно-бубонная Глазо-бубонная Ангинозно-бубонная Абдоминальная Легочная Генерализованная дек 2014 д. м. н. Таран Татьяна Викторовна 24
Профилактика и лечение туляремии v Специфическая профилактика – живая противотуляремийная вакцина Эльберта-Гайского. Иммунизируют население эндемичных районов и сотрудников специализированных лабораторий. v Лечение – антибиотики: аминоглюкозиды, тетрациклины дек 2014 д. м. н. Таран Татьяна Викторовна 25
Диагностика туляремии Экспресс-методы – ПЦР Бактериоскопический метод; Серологический метод - реакция агглютинации, РНГА с сывороткой больного, РИФ, РСК на холоде; Биологическая проба на белых мышах для последующего выделения возбудителя на свернутой желточной, желточно- агаровой среде. Кожно-аллергическая проба с тулярином. Бактериологический метод – выделение чистой культуры и идентификация дек 2014 д. м. н. Таран Татьяна Викторовна 26
Бруцеллез – острое или хроническое (чаще) инфекционное зоонозное заболевание, которое характеризуется интоксикацией, преимущественным поражением опорно- двигательного аппарата, нервной, сердечно- сосудистой, мочеполовой систем и других органов, аллергизацией организма, затяжным течением, приводящим, как правило, к инвалидизации. дек 2014 д. м. н. Таран Татьяна Викторовна 27
Бруцеллез v Бруцеллы – мелкие (0, 5 -0, 7 х 0, 6 -1, 5 мкм), неподвижные, грамотрицательные кокковидные палочки, капсул не образуют, могут формировать нежную микрокапсулу v Строгие аэробы, некоторые штаммы нуждаются в повышенной концентрации CO 2. v Характерен медленный рост на специальных средах (неделя и более) – агар Альбими, кровяной агар и др. v Бруцеллы хорошо культивируются в жировых (неоплодотворенных) яйцах, желточном мешке 10 -12 дневных куриных эмбрионов v Имеют соматический и капсульный антигены дек 2014 д. м. н. Таран Татьяна Викторовна 28
МУК 4. 2. 3010 -12 Род Brucella состоит из 6 самостоятельных видов: B. melitensis – 3 биовара, B. abortus – 7 биоваров, B. suis – 5 биоваров, B. neotomae, B. ovis, B. canis. Подкомитет по таксономии бруцелл (2005) B. ceti (китоотбразные), B. pinnipedialis (ластоногие) B. microti (серая полёвка) B. inopinata дек 2014 д. м. н. Таран Татьяна Викторовна 29
Эпидемиологическая классификация административных территорий ЮФО по уровню заболеваемости бруцеллезом за 2001 – 2014 гг. дек 2014 д. м. н. Таран Татьяна Викторовна 30
Факторы патогенности бруцелл Ø Бруцеллы являются факультативными внутриклеточными паразитами млекопитающих, включая человека. Ø Обладают высокой инвазивной способностью, Ø образуют фермент агрессии гиалуронидазу. Ø Основными факторами вирулентности являются эндотоксин и капсула Ø Высокая способность к аллергизации человека Иммунитет при бруцеллезе клеточно-гуморальный, в основном нестерильный и относительный. После выздоровления иммунитет угасает, возможна реинфекция дек 2014 д. м. н. Таран Татьяна Викторовна 31
Особенности клиники и лечения современного бруцеллеза Мягкое, «доброкачественное течение» острой фазы заболевания Очаговые поражения – реже и единичные Преобладание реактивных синовиитов Сочетанное поражение вегетативной и костно-суставной систем Рост резистентности бруцелл к тетрациклинам Чувствительность бруцелл к макролидам и фторхинолонам Лечение: антибиотики – тетрациклин, доксициклин, рифампицин, левомицетин, а также восстановительная и стимулирующая терапия. дек 2014 д. м. н. Таран Татьяна Викторовна 32
Для профилактики и лечения бруцеллеза Вакцина бруцеллезная живая, филиал ФГУП НПО «Микроген» г. Омск; Вакцина бруцеллезная лечебная жидкая, ФГУ « 48 ЦНИИ МО РФ» - (убитая) дек 2014 д. м. н. Таран Татьяна Викторовна 33
Бактериологическая диагностика бруцеллёза Бактериологический метод Биологический метод Б/м, п/к 0, 5 мл М/св, п/к 1 мл Кровь, моча, костный мозг, Загрязнённый СМЖ, желчь, пунктаты материал Вскрытие – 21 сут Вскрытие – 30 сут Бифазная Паренхиматозные среда (по СТБ Среда с ГВ Среды с аб органы; лимфоузлы Кастанеда) (5 групп) Чистая культура Межвидовая дифференциация Идентификация Потребность в СО 2 Окраска по Граму, Козловскому B R Продукция H 2 S Характер роста U на питательных средах C Рост на средах с основными E красителями РА с поливалентной L Чувствительность к бактериофагам бруцеллёзной сывороткой L A РА с моноспецифическими сыворотками МФА ОВ метаболизм дек 2014 д. м. н. Таран Татьяна Викторовна 34
Лабораторная диагностика бруцеллеза Экспресс-методы (ПЦР – выявление ДНК возбудителя) бактериологический метод – выделение культуры биологический метод (б. м. или м. св. вб заражают кровью) серологический метод (реакция Райта – титр 1: 200 – реакция Райта 1: 400; Хеддельсона; РСК ) аллергологический метод (вк проба Бюрне с бруцеллином) дек 2014 д. м. н. Таран Татьяна Викторовна 35
Основные иммуносерологические реакции при диагностике бруцеллеза ● реакция Хеддельсона (пластинчатая РА) ● реакция Райта (пробирочная РА) – диагностический титр 1: 100 ● РПГА – диагностический титр 1: 100 ● реакция Кумбса (неполные антитела + антиглобулиновая сыворотка) ● ИФА Аллергическая проба. Реакция Бюрне – в/к проба с бруцеллином, через 6 -8 ч, редко 24 ч. и сохраняется 40 -50 ч. Реакция Бюрне является строго специфической. дек 2014 д. м. н. Таран Татьяна Викторовна 36
Сибиреязвенная бацилла (Bacillus anthracis) Ø Bacillus anthracis (от греч. anthrax - злокачественный карбункул) - вызывает сибирскую язву - острую зоонозную инфекцию, характеризующуюся тяжелой интоксикацией, поражением кожи, лимфатических узлов и других тканей. Ø Человек заражается контактным путем (при уходе за больными животными, убое, переработке животного сырья), реже алиментарным путем (при употреблении мяса и других животноводческих продуктов), воздушно- пылевым путем. Ø Резервуар и источник инфекции: крупный и мелкий рогатый скот, лошади, верблюды, свиньи. Ø Споры B. anthracis длительно сохраняются в почве и могут служит источником инфекции. дек 2014 д. м. н. Таран Татьяна Викторовна 37
Морфология Грамположительные спорообразующие прямые палочки (0, 5 -2, 5 х 1, 2 -10 мкм) с обрубленными или слегка закругленными концами, образующие цепочки. Неподвижны. Аэробы или факультативные анаэробы. Могут образовывать капсулы. Споры располагаются центрально. Они чрезвычайно устойчивы и сохраняются в окружающей среде десятки лет. дек 2014 д. м. н. Таран Татьяна Викторовна 38
Морфология сибиреязвенного микроба дек 2014 д. м. н. Таран Татьяна Викторовна 39
Капсула B. anthracis (1000×) Споры B. anthracis дек 2014 д. м. н. Таран Татьяна Викторовна 40
1 Bacillus anthracis, Sporen, Raster-Elektronenmikroskopie. Maßstab = 500 nm 2 Bacillus anthracis, Sporen, Transmissions-Elektronenmikroskopie, Maßstab = 200 nm This scanning electron micrograph shows macrophages infected with Bacillus anthracis дек 2014 41 д. м. н. Таран Татьяна Викторовна
Резистентность спор Bacillus anthracis Резистентность спор При медленном высушивании наступает спорообразование и микроб не гибнет. При температуре ниже 12 и выше 42 о. С, а также в живом организме или невскрытом трупе, в крови и сыворотке животных споры не образуются. В запаянных ампулах с бульонными культурами споры могут оставаться жизнеспособными и вирулентными до 63 лет, в почве – более 50 лет. Этиловый спирт 25 -100 % убивает споры в течение 50 дней и более, 5 % фенол, 5 -10 % р-р хлорамина – от несколько часов до нескольких суток, 2 % раствор формалина – через 10 -15 мин, 3 % р-р перекиси водорода – через 1 ч. Сухой жар при 120 -140 o. С убивает споры через 2 -3 ч, при 150 o. С – через 1 ч, текущий пар при 100 o. С – через 12 -15 мин, кипячение – через 1 ч. , автоклавирование при 110 o. С – за 5 -10 мин, дек 2014 д. м. н. Таран Татьяна Викторовна 42
Типичный рост Bacillus anthracis в бульоне Рост в полужидком агаре через 18 -20 часов – «комочек ваты» на дне пробирки При посеве в столбик желатина на 2 - 5 -е сут появляется желтовато-белый стержень. Культура напоминает елочку, перевернутую верхушкой вниз. Постепенно верхний слой желатин начинает разжижаться, принимая сначала форму воронки, затем мешочка дек 2014 д. м. н. Таран Татьяна Викторовна 43
B. cereus, B. megaterium, B. Тест B. anthracis mycoides, B. subtilis Не патогенны для лабораторных Патогенна для лабораторных Патогенность животных, за исключением B. животных cereus (б. м. ) Образует массивную с четкими Капсулообразование Капсулу не образуют. контурами капсулу. На агаре с пенициллином возбудитель растет в виде Феномен «жемчужного ожерелья» «Жемчужное ожерелье» цепочек, напоминающих отсутствует. ожерелье из жемчуга. Лизируется сибиреязвенным Лизис сибиреязвенный фагом Лизабельность фагом фагом. отсутствует. Иммунофлюоресцентный тест Положительный Отрицательный Подвижность Неподвижна Подвижны Как правило не гемолизирует Гемолитическая активность эритроциты барана, или Гемолизирует эритроциты барана. лизирует очень медленно. Желток куриного яйца свертывает медленно или B. cereus интенсивно синтезирует Лецитиназная активность вообще не свертывает (левый лецитиназу (верхний сектор) сектор) Образование фосфатазы д. м. н. Таран Татьяна Викторовна дек 2014 Отсутствует Имеется 44
Формирование спор B. anthracis Макрофаг (синий) «заглатывает» цепочку из бактерий Bacillus anthracis дек 2014 д. м. н. Таран Татьяна Викторовна 45
Факторы патогенности Bacillus anthracis Образование капсулы, обладающей антифагоцитарной активностью и адгезивными свойствами; Инвазивные свойства микроба обусловлены капсульным полипептидом d-глутаминовой кислоты и экзоферментами. Bacillus anthracis образует сложный экзотоксин, состоящий из трех компонентов: эдематозный (воспалительный) фактор (ЕF), протективный антиген (РА) и летальный фактор (LF) или факторы I, III. Ø Эдематозный фактор – местная воспалительная реакция – отек и разрушение тканей. Ø Протективный антиген –обладает выраженным иммуногенным действием. Ø Летальный фактор в смеси с протективным вызывает гибель крыс, белых мышей и морских свинок. Ø Каждый из трех факторов обладает выраженной антигенной функцией и серологически активен. дек 2014 д. м. н. Таран Татьяна Викторовна 46
Патогенез сибиреязвенной инфекции v Воротами инфекции для сибирской язвы чаще является повреждённая кожа. В редких случаях бацилла внедряется через слизистые оболочки дыхательных путей или ЖКТ. v На месте внедрения возбудителя в кожу возникает сибиреязвенный карбункул в виде очага серозно- геморрагического воспаления с некрозом, отёком прилегающих тканей и регионарным лимфаденитом. v Местный патологический процесс обусловлен действием экзотоксина сибиреязвенной бациллы, отдельные компоненты которого вызывают выраженные нарушения микроциркуляции, отёк тканей и коагуляционный некроз. дек 2014 д. м. н. Таран Татьяна Викторовна 47
Патогенез сибиреязвенной инфекции v Вне зависимости от входных ворот инфекции первая стадия представляет собой локализованное поражение регионарных лимфатических узлов, вторая стадия — генерализацию процесса. v Генерализация инфекции с прорывом возбудителей сибирской язвы в кровь и развитием септической формы происходит при кожной форме сибирской язвы чрезвычайно редко. v Сибиреязвенный сепсис обычно развивается при внедрении возбудителя через слизистые оболочки дыхательных путей или желудочно-кишечного тракта. v В этих случаях нарушение барьерной функции трахеобронхиальных или мезентериальных лимфатических узлов приводит к генерализации процесса. Бактериемия и токсинемия могут явиться причиной развития инфекционно-токсического шока. дек 2014 д. м. н. Таран Татьяна Викторовна 48
Сибиреязвенный карбункул Буллезная форма сибирской язвы дек 2014 д. м. н. Таран Татьяна Викторовна 49
дек 2014 д. м. н. Таран Татьяна Викторовна 50
Формирование колоний сибиреязвенного микроба на питательном агаре через 16 -18 часов дек 2014 д. м. н. Таран Татьяна Викторовна 51
Лизис B. anthracis фагом дек 2014 д. м. н. Таран Татьяна Викторовна 52
Микробиологическая диагностика сибирской язвы v Экспресс-метод – ПЦР v Бактериоскопический метод - мазки из патологического материала окрашивают по Граму и для выявления капсул - по Романовскому-Гимзе или раствором метиленового синего. v Бактериологический метод с выделением чистой культуры на МПА и МПБ, кровяном агаре. Ставят тесты "жемчужного ожерелья", чувствительность к фагу. v Биологическая проба на морских свинках и мышах. v Кожно-аллергичекая проба с антраксином. v Реакция термопреципитации по Асколи при определении сибереязвенного гаптена в загнившем материале. дек 2014 д. м. н. Таран Татьяна Викторовна 53
Профилактика и лечение сибирской язвы Специфическая профилактика- живая сибиреязвенная вакцина СТИ Лечение – антибиотики: пенициллин, ампициллин, доксициклин и др. В тяжелых случаях – введение лошадиной антитоксической сыворотки дек 2014 д. м. н. Таран Татьяна Викторовна 54
Биологические патогены обладают рядом уникальных характеристик: широко распространены в природе живые, размножающиеся легкое и дешевое производство разнообразны: более 20 патогенов могут использоваться для создания БО не могут быть обнаружены дистанционно существующими методами широко используются в легитимных биологических исследованиях и фармацевтической или биотехнологической промышленности дек 2014 д. м. н. Таран Татьяна Викторовна 55
Образцы патогенов, которые могут эффективно использоваться как БПА: вирусы оспы, Венесуэльского лошадиного энцефаломиелита, желтой лихорадки, Эбола и Марбург бактерии B. anthracis Y. pestis, F. tularensis дек 2014 д. м. н. Таран Татьяна Викторовна 56
Глобальные правила биобезопасности должны включать: регистрацию и лицензирование предприятий, работающих с опасными биологическими агентами, на основании перечня патогенов и токсинов физическую безопасность и контроль доступа в лаборатории и к коллекциям культур систему контроля и учета патогенов и токсинов испытательный срок для лабораторного персонала чрезвычайный план реагирования в случае нарушения биобезопасности дек 2014 д. м. н. Таран Татьяна Викторовна 57
Третье издание (2004) предлагает концепции биобезопасности – защиты микробиологических фондов от хищения, потери или диверсии, что может привести к противоправному использованию этих агентов в целях причинения ущерба здоровью человека. дек 2014 д. м. н. Таран Татьяна Викторовна 58
Благодарю за внимание дек 2014 д. м. н. Таран Татьяна Викторовна 59
дек 2014 д. м. н. Таран Татьяна Викторовна 60
дек 2014 д. м. н. Таран Татьяна Викторовна 61
Схема эпидемического процесса при антропонозных и зоонозных инфекциях. Эпидемический процесс – непрерывная цепь последовательно возникающих одно из другого инфекционных состояний (больные, носители) либо эпидемических очагов (Громашевский, 1965). Антропонозы Источник возбудителя инфекции Зоонозы Человек Эпизоотия Животные Факторы передачи Восприимчивое население Чума Бруцеллез Желтая лихорадка. Человек Сибирская Человек КГЛ язва Туляремия Прекращение заболевания людей и ликвидация Прекращение эпидемического эпидемического процесса не ведет к прекращению процесса ведет к прекращению циркуляции возбудителя в природе, т. к. он циркуляции возбудителя в сохраняется как биологический вид в результате природе, ликвидации инфекции эпизоотического процесса. 62 дек 2014 д. м. н. Таран Татьяна Викторовна
Материал для исследования на бруцеллез: от людей: кровь, костный мозг, спинномозговая жидкость, моча, желчь, суставная жидкость (при артритах), гной (при абсцессах), секционный материал от животных: кровь, абортированные плоды, околоплодные оболочки или желудок плода с его содержимым, лимфатические узлы, влагалищные выделения, молоко; пищевые продукты: сливки, сыры, творог, мясо объекты окружающей среды: вода, почва, навоз дек 2014 д. м. н. Таран Татьяна Викторовна 63
Тесты межвидовой дифференциации бруцелл ◙ отношение культур к повышенному содержанию в атмосфере углекислого газа ◙ образование сероводорода ◙ редуцирующая активность в отношении основных красителей (фуксин и тионин) ◙ агглютинация моноспецифическими сыворотками ◙ лизис бруцеллезным бактериофагом Тб дек 2014 д. м. н. Таран Татьяна Викторовна 64
Потребность бруцелл к повышенному содержанию в атмосфере углекислого газа B. melitensis нет B. abortus да B. suis нет дек 2014 д. м. н. Таран Татьяна Викторовна 65
Продукция бруцеллами сероводорода B. melitensis (1 биовар) нет B. abortus (1 биовар) 5 -7 мм B. suis (1 биовар) 15 -20 мм дек 2014 д. м. н. Таран Татьяна Викторовна 66
Редуцирующая активность бруцелл в отношении основных красителей Тионин (20 Фуксин (20 мкг/мл) B. melitensis Есть (1 биовар) B. abortus Нет Есть (1 биовар) B. suis (1 биовар) Есть Нет дек 2014 д. м. н. Таран Татьяна Викторовна 67
РА бруцелл с моноспецифическими сыворотками сыворотка anti-abortus anti-melitensis B. melitensis 1: 20 ( не менее, отрицательная (1 биовар) чем на 2 креста) B. abortus 1: 20 ( не менее, чем отрицательная (1 биовар) на 2 креста) B. suis 1: 20 ( не менее, чем отрицательная (1 биовар) на 2 креста) дек 2014 д. м. н. Таран Татьяна Викторовна 68
Поэтапное развитие иммунологической реактивности у больных бруцеллезом 180 10 сут 30 сут 60 сут 90 сут 120 сут сут РХ + + + + + РА – + + – – РПГА + + + + + РК – + + + + Проба – + + + + Бюрне ИФА – + + + + дек 2014 д. м. н. Таран Татьяна Викторовна 69
Подходы к использованию лабораторных методов исследования при бруцеллезе Цель Посев Проба РХ РА РПГА РК ИФА исследования крови Бюрне Острый и если все подострый + + + тесты + отриц, бруцеллез то + Перед + + вакцинацией Эпидобсле- + + + дование Хронический + + + бруцеллез дек 2014 д. м. н. Таран Татьяна Викторовна 70
Бруцеллезные диагностические препараты и питательные среды Ген. Бру Тест-система для выявления ДНК Brucella spp. методом ПЦР (Рос. НИПЧИ «Микроб» ); Иммуноглобулины флуоресцирующие, ( «Медгамал» ); Диагностикум бруцеллезный жидкий для РА; ( «Медгамал» , ФГУЗ Став. НИПЧИ); Бактериофаги бруцеллезные жидкие (ФГУЗ Став. НИПЧИ); Аллерген бруцеллезный жидкий (бруцеллин), филиал ФГУП НПО «Микроген» г. Омск; Питательные среды для накопления, выделения и культивирования бруцелл, филиал ФГУП НПО «Микроген» ( г. Махачкала) дек 2014 д. м. н. Таран Татьяна Викторовна 71

